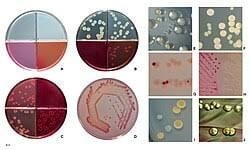
image 1

E. coli was first identified by the German pediatrician Theodore Escherich during his studies of the intestinal flora of infants. This is a group of bacteria which is normally found in the GI tract, urinary tract and other parts of your body without hurting you. But under certain conditions, many strains can cause infections by adhering to your cells and realizing toxins. It causes a broad spectrum of disease in humans such as UTI, enteric illness, neonatal sepsis, hemolytic uremic syndrome. It is used as a control organism for the testing of the efficacy of antimicrobial agents, disinfectants and considered as an indicator organism of the fecal contamination of water.

Taxonomy and Classification
Domain: Bacteria
Kingdom: Pseudomonadati
Phylum: Pseudomonadota
Class: Gammaproteobacteria
Order: Enterobacterales
Family: Enterobacteriaceae
Genus: Escherichia
Species: E. coli
Kinds of E. coli
| Kind of E. coli | Common Symptoms | Most affected group | Major Sources |
| STEC (Shiga toxin producing E. coli) | Vomiting, Diarrhea with blood, Severe stomach cramps | Children less than 5 years old | Contaminated foods (especially leafy greens vegetables and ground beef), Animals (especially cattle), their environment or poop, Unsafe water |
| ETEC (Enterotoxigenic E. coli) | Watery diarrhea, Stomach cramps, Vomiting | 18-35 years adults and International Travelers | Food, Water or ice contaminated with animal poop or infected person’s poop |
| EPEC (Enteropathogenic E. coli) | sometimes low fever, sometimes vomiting, Watery diarrhea which may sometimes last more than 2 weeks | Children less than 1 year | Infected person’s poop |
| EIEC (Enteroinvasive E. coli) | Watery diarrhea having blood sometime, fever | International travelers and children | Infected person’s poop |
| EAEC (Enteroaggregative E. coli) | Watery diarrhea with mucus sometime, diarrhea can last more than 2 weeks, sometime fever and vomiting | Children, HIV infected person, International travelers | Unknown |
| DAEC (Diffusely Adherent E. coli) | Watery diarrhea | 3-5 years children | Unknown |
Morphology and Microscopy
- Gram negative, straight, rod-shaped
- Approximately 1-3µ*0.4-0.7µ arranged singly or in pairs
- Non-sporing, Non-acid fast
- Capsule and Fimbriae present
- Motile by peritrichous flagella but some strains are non-motile.
- Aerobic and Facultative Anaerobes
After Gram staining, it appears as pink rod shaped either singly or in pairs under microscope.
Cultural and Growth Characteristics
- Grow on most media under anaerobic condition.
- Optimum temperature: 37˚C
- Optimum pH: 7
- Nutrient Agar: Circular, 1-3mm, Convex, smooth to rough surface, mucoid, grayish white in color, translucent or opaque.
- Eosin Methylene Blue (EMB) Agar: Circular, 2-3mm, Convex, smooth to rough surface, mucoid, green metallic sheen in color, opaque.
- MacConkey Agar: Circular, 2-3mm, Convex, smooth to rough surface, mucoid, pink in color, opaque.
- Blood Agar: Circular, 1-3mm, Convex, smooth to rough surface, mucoid, green metallic sheen in color, opaque, β-hemolysis.
Source: https://en.wikipedia.org/wiki/Escherichia_coli
Biochemical and Identification Tests
| Tests | Properties |
| Gram Staining | Gram Negative |
| Catalase | Positive |
| Oxidase | Negative |
| Indole | Positive |
| MR (Methyl Red) | Positive |
| VP (Voges Proskauer) | Negative |
| Citrate | Negative |
| H2S | Negative |
| Motility | Motile |
| Capsule | Variable |
| Gas | Positive |
| Gelatin Hydrolysis | Negative |
| O/F | Fermentative |
| Urease | Negative |
| Hemolysis | Some strains show hemolysis |
| Fermentation of | |
| Glucose | Positive |
| Fructose | – |
| Lactose | Positive |
| Mannitol | Positive |
| Dnase | Negative |
| Arabinose | Positive |
| Sucrose | Variable |
| Enzymatic Reactions | |
| Alkaline Phosphatase | – |
| Arginine Dehydrolase | Variable |
| Hyalurodinase | – |
| Lipase | – |
| Ornithine Decarboxylase | Variable |
Pathogenesis and Virulence Factors
- E. coli forms a part of normal intestinal flora of man and animals and is excreted in feces in very large numbers which then contaminate soil and water.
- Infection is acquired by consumption of these contaminated food and water.
- It is an invasive bacterium which colonizes the human intestine but under certain circumstances directly invades the intestinal mucosa or produces toxins that cause intestinal infections.
- The bacteria can also enter the blood stream and cause septicemia, meningitis and other systemic manifestation.
- These bacteria under certain circumstances, directly invade urinary tract causing UTI or can cause intra-abdominal infections.
Toxins
Various strain of E. coli produces various types of toxins which are explained below:
- Enterotoxigenic strains of E. coli produce two types of toxins:
Heat Labile Toxin (LT)
- Is a heat sensitive protein.
- Can be destroyed by heating for 30 min at 65˚C.
- Composed of 5 β sub unit (used for binding) and 1 α sub unit (which has the toxic enzymatic activity).
- α sub unit activated to α1 and α2.
- Subunit α1 is responsible for activating adenyl cyclase in the enterocytes forming cyclic adenosine 5 monophosphate.
- It then increases the outflow of water and electrolytes in the gut lumen causing diarrhea.
Heat Stable Toxin (ST)
- Is a poorly immunogenic and low weight polypeptide.
- Possess two major classes i.e. ST-I and ST-II.
- ST-1 is not destroyed by heating for 30 min at 100˚C.
- It is responsible for activation of guanylate cyclase causing the increased production of cyclic guanosine mono phosphate (cGMP) and subsequent hypersecretion.
- Some strains of E. coli produce ST-II.
- Mechanism of action of ST-II is not known till now, but it does not act through cGMP.
- These enterotoxin alone is not sufficient to cause diarrhea.
Haemolysin
- Haemolysin is produced by many strains of E. coli which is responsible for lysis of RBCs of some species.
- In experimental animals, hemolytic strains are more virulent than that of non hemolytic strains.
- It is believed that hemolytic ones obtain iron from erythrocytes that are lysed in host.
Verocytotoxin
- Some strain produces cytotoxin similar to the Shiga toxin that are produced by Shigella dysentriae type I.
- This toxin is responsible for Hemolytic Uremic Syndrome and food borne illness.
- This toxin is named Verocytotoxin because it is cytotoxic to Vero cells (African Monkey Kidney cell).
Antigenic Structure
E. coli possesses mainly 4 major antigens as follows:

Source: https://www.intechopen.com/chapters/84764
H or Flagellar Antigen:
- Is heat and alcohol sensitive proteins found on flagella.
- Is genus specific and not shared by other enter0-bacteria.
- Is found as monophasic but rarely sometime as diphasic.
- Total 75 H antigens are known till now.
O or Somatic Antigen:
- Is heat stable and resistant to heating up to 2 hours.
- Is a lipopolysaccharide complex and is found on the cell wall.
- It shows cross-reaction with related genera like Shigella, Salmonella, Yersinia and Citrobacter and with individual E. coli O antigen.
- Total 173 O antigens are known till date.
K or Capsular Antigen:
- Is heat sensitive acidic polysaccharide antigen found in the envelope.
- Encloses the O antigen and can interfere with O antigen detection so to overcome this problem the bacterial suspension is boiled to remove K antigen.
- Can contribute to virulence by inhibiting phagocytosis.
- Is poor activator of complement.
- Total 103 K antigens are known.
- Are of two types: I and II. K I antigens shows cross reaction with Haemophilus influenzae and Neisseria meningitidis.
F or Fimbrial Antigen:
- Is heat sensitive proteins found on the fimbriae.
- Contribute to virulence of the bacteria.
Epidemiology and Transmission
In 1982 during an outbreak investigation of hemorrhagic colitis, E. coli O157:H7 was first identified. After 1993, E. coli O157 was recognized as a very important and threatening pathogen when there was a large multistate E. coli outbreak connected to ground beef patties distributed from a fast-food cafe. In his way, till 1994 E. coli O157 became nationally notifiable bacteria and by 2000, reporting of infection by E. coli was compulsory in 48 states. In USA, each year about 73,480 illnesses is caused by E. coli causing about 2,168 hospitalizations with annually about 61 deaths. STEC (Shiga Toxin producing E. coli) are responsible for about 265,000 illnesses, with about 3,600 hospitalizations and 30 deaths annually in United States according to Centers for Disease Control and Prevention. Infections due to E. coli can be through consumption of contaminated food or water, contact with infected animals and their feces.
E. coli transmission occurs by various methods:
- Consumption of raw or unwashed vegetables and fruits
- Drinking contaminated water and unpasteurized milk or juice.
- Consumption of undercooked meat especially ground beef.
- Swimming in contaminated water
- To travelers who travels to area with poor sanitation and hygiene
- Coming in contact with farm animals or their feces
Clinical Manifestations
E. coli causes various symptoms based on the type and severity of the infection. Various sign and symptoms are as follows:
- Urinary symptoms like burning, urgency, frequency and sometimes blood in urine.
- Diarrhea
- Abdominal pain
- Fever
- Dehydration
The symptoms appear within 3-4 days after exposure and can lasts up to 10 days. Most of the infections recover but some can develop serious life-threatening conditions. Below are some serious complications caused by E. coli:
- Hemolytic Uremic Syndrome
- Acute Renal Failure
- Hemolytic Anemia
- Thrombocytopenia
- Seizure, Stroke and Coma
Laboratory Diagnosis
Sample Collection
Based on the site of infection, type of sample is determined
| Infection | Sample |
| Acute Diarrhea | Feces and Rectal swab |
| Urinary tract infection | Urine |
| Pyogenic Meningitis | Cerebro Spinal Fluid (CSF) |
| Wound | Pus |
Microscopy (Gram’s Staining)
- Appears as pink colored rod –shaped with pus cells in background.
Culture
- Specimens are inoculated on the suitable media.
- Then the inoculated plates are incubated at 48-72˚C for about 24 hrs.
- On Nutrient Agar: Colorless, smooth surface, large colonies.
- On Blood Agar: moist non-hemolytic with creamy white colonies.
- On MacConkey Agar: mucoid pink lactose fermenting colonies.
Biochemical Tests
| Biochemical Test | Result |
| Catalase | Positive |
| Oxidase | Negative |
| Glucose (Gas) | Positive |
| Lactose (Acid) | Positive |
| Indole | Positive |
| MR (Methyl Red) | Positive |
| VP(Voges Proskauer) | Negative |
| Citrate Utilization | Negative |
| Urease | Negative |
| H2S production | Negative |
| Nitrate Reduction | Positive |
- After culture, colonies from incubated plates are performed for biochemical tests and identified as E. coli based on following results:

Source: https://www.sigmaaldrich.com/NP/en/technical-documents/technical-article/food-and-beverage-testing-and-manufacturing/microbiological-analysis-for-food-and-beverage/differentiation-of-e-coli-coliforms?srsltid=AfmBOorLd-ayHxFEwUhhLP-b8HJksnS05-pZy4Fhq8qnSO2opcyZly7is
Antibiotic Susceptibility Test
- For antibiotic susceptibility test, disc diffusion method is used.
Stool PCR Test
- PCR assay is used to detect very tiny amounts of DNA of E. coli present in stool sample
Treatments
Hydration
- Drink plenty of water along with electrolyte solution as suggested by doctor
Rest
- Helps to promote recovery and increase immunity that fight against the infection.
- This is especially suggested in case of gastroenteritis since patients can feel weaker having several rounds of diarrhea.
Antibiotics
- Nitrofurans like Nitrofurantoin
- Sulfonamides like Sulfamethoxazole+trimethoprim
- Penicillins like Amoxicillin or Ampicillin
- Cephalosporins such as Cephalexin
- Aminoglycoside like Gentamicin
- Quinolones such as Levofloxacin or Ciprofloxacin
- Phosphonic acid derivatives like Fosfomycin
- Carbapenems
- Monobactams
- Fluoroquinolones
Analgesics
- Acetaminophen may be used which help to reduce fever.
Antispasmodics
- To relieve intestinal or urinary tract cramps antispasmodics medications such as Scopolamine can be used.
Prevention and Control
- One of the best ways of prevention of E. coli infection is by keeping your hands clean and sanitized.
- Always maintain food safety by properly cleaning and cooking foods before consumption.
- Avoid drinking unsafe and contaminated water.
- While travelling always maintain proper hygiene and sanitation.
- While swimming or playing in ponds, rivers or streams avoid swallowing water.
- Always consume pasteurized milk and juices.
Antimicrobial Resistance
The development of resistance in E. coli is increasing in various countries over the past decades, and it has become worrying issue not only in human but also in animals. Though E. coli is susceptible to almost all antibiotics, but this pathogen has a great capacity to assemble resistance gene, especially through horizontal gene transfer. Mechanisms through which E. coli develop resistance correlate with the acquisition of genes coding for extended-spectrum β-lactamases (providing resistance to broad-spectrum Cephalosporins), 16S rRNA methylases (providing resistance to aminoglycosides), carbapenemases (providing carbapenems resistance), plasmid-mediated quinolone resistance genes (conferring fluoroquinolones resistance), and mcr genes (conferring resistance to polymyxins). Though the spread of carbapenemase gene is mainly seen in human but it is poorly recognized in animals. Resistance to colistin in E. coli is related to overuse of colistin in veterinary medications. The cross transfer among human and animal is still controversial even though investigation of genome shows that the extended-spectrum β-lactamase producers in animals are different from those encountered in human. Similarly, in animal, E. coli show resistance to other important old antibiotics like tetracyclines, sulfonamides, trimethoprim, fosfomycin. Multi-resistance plasmids, mobile genetic elements like transposons and gene cassettes in class1 and class2 integrous play an important role in resistant genes dissemination.
Conclusion
E. coli is a bacterium that forms part of normal intestinal flora but under certain circumstances may cause human tract infections and is responsible for various diseases, such as traveler’s diarrhea and sepsis. Most of the pathogenic strains produce toxins which can lead to severe gastrointestinal symptoms and complications leading to acute renal failure, seizure, stroke and even coma. This organism is known for its fast-growing rate in media and its adaptability and for ease of handling. Among various pathogens, this is the most studied and well-understood because of which it is widely used in research, used as an indicator organism which open up new pathways for further investigations.
References
Cleveland Clinic. (2023, November 22). E. coli infection. Cleveland Clinic. https://my.clevelandclinic.org/health/diseases/16638-e-coli-infection
Biology Discussion. (n.d.). Escherichia coli (E. coli): Meaning, morphology and characteristics. Biology Discussion. https://www.biologydiscussion.com/bacteriology/systematic-bacteriology/escherichia-coli-e-coli-meaning-morphology-and-characteristics/30821
Basavaraju, M., & Gunashree, B. S. (2022). Escherichia coli: An overview of main characteristics. In Escherichia coli – Old and new insights. IntechOpen. https://www.intechopen.com/chapters/84764
Aryal, S. (2022, August 10). Biochemical test and identification of E. coli. MicrobiologyInfo.com. https://microbiologyinfo.com/biochemical-test-and-identification-of-e-coli/
Centers for Disease Control and Prevention. (2024, May 14). Kinds of E. coli. U.S. Department of Health and Human Services. https://www.cdc.gov/ecoli/about/kinds-of-ecoli.html
Rangel, J. M., Sparling, P. H., Crowe, C., Griffin, P. M., & Swerdlow, D. L. (2005). Epidemiology of Escherichia coli O157:H7 outbreaks, United States, 1982–2002. Emerging Infectious Diseases, 11(4), 603–609. https://doi.org/10.3201/eid1104.040739
Eissa, M. E. (2024). Escherichia coli: Epidemiology, impact, antimicrobial resistance and prevention: A review. Journal of Public Health and Community Medicine, 1(1), 39–49. https://doi.org/10.5455/JPHCM.20240110064652
Tua Saúde. (2025, April). E. coli treatment: 6 treatment options & natural remedies. Tua Saúde. https://www.tuasaude.com/en/e-coli-treatment/
Mueller, M., Rausch-Phung, E. A., & Tainter, C. R. (2025). Escherichia coli infection. In StatPearls. StatPearls Publishing. Retrieved February 9, 2026, from https://www.ncbi.nlm.nih.gov/books/NBK564298/
Centers for Disease Control and Prevention. (2024, May 14). How to prevent E. coli infection. U.S. Department of Health & Human Services. https://www.cdc.gov/ecoli/prevention/index.html
Poirel, L., Madec, J.-Y., Lupo, A., Schink, A.-K., Kieffer, N., Nordmann, P., & Schwarz, S. (2018). Antimicrobial resistance in Escherichia coli. Microbiology Spectrum, 6(4). https://doi.org/10.1128/microbiolspec.ARBA-0026-2017
Wu, D., Ding, Y., Yao, K., Gao, W., & Wang, Y. (2021). Antimicrobial resistance analysis of clinical Escherichia coli isolates in neonatal ward. Frontiers in Pediatrics, 9, Article 670470. https://doi.org/10.3389/fped.2021.670470
